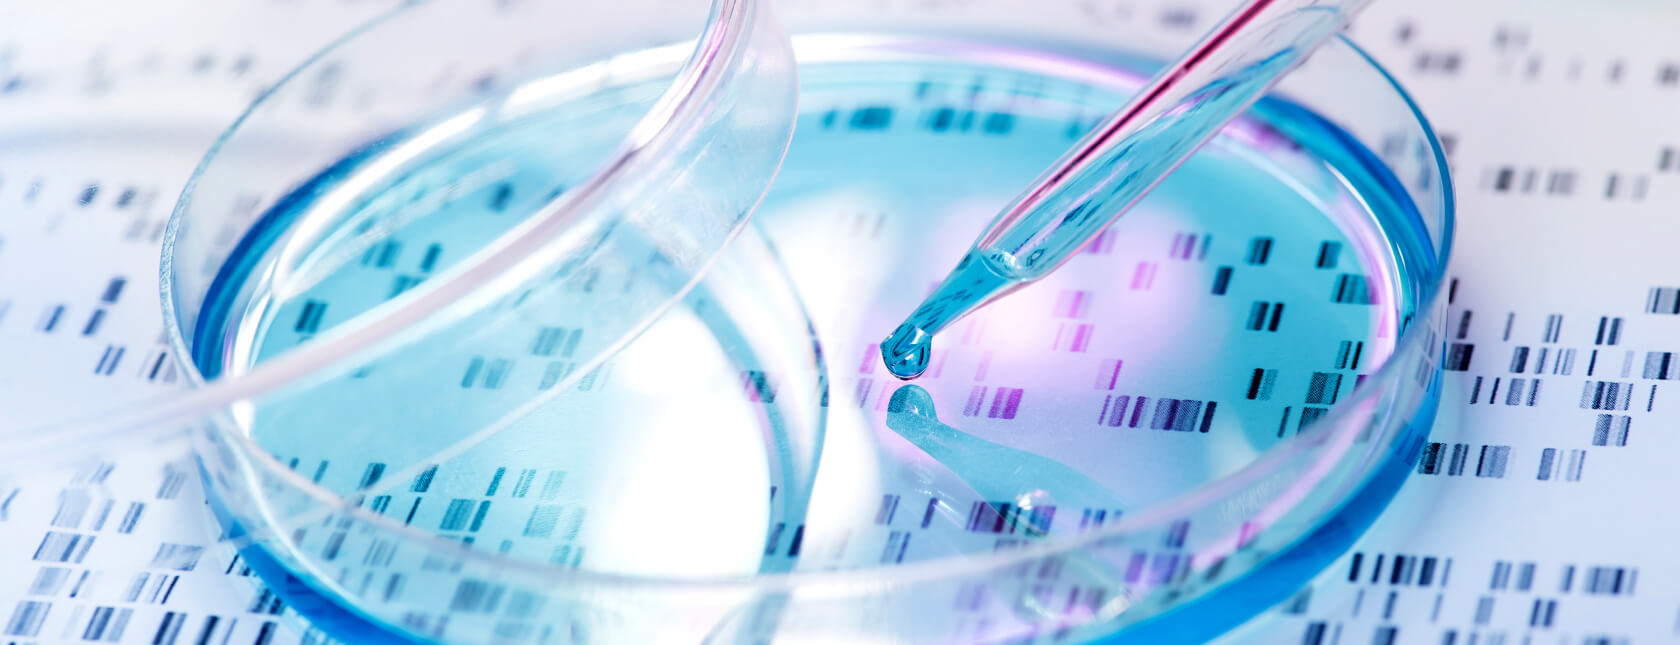
醫療器材電氣安全法規概述與實務討論研習課程

醫療器材法規訓練課程
醫療器材的生產是一個受到嚴格監管的業務。幾乎在所有國家,對於大多數醫療產品,都有製造商需要符合的要求和標準。DNV作為獨立的第三方機構,我們檢查系統、產品、人員與相關國際或國家標準的符合性,提供醫材廠商完善的稽核和評估服務。
醫療器材法規訓練課程
Trainings

ISO 10993 生物相容性法規概述含17&18

ISO 13485:2016 內部稽核員訓練課程

ISO 14971:2019 風險管理實務研習

MDR 技術文檔與品質管理系統

MDR 歐盟醫療器材法規 - 品質管理系統內部稽核員研習課程

MDR 歐盟醫療器材法規 內部稽核員研習課程

MDR 歐盟醫療器材法規-一般安全有效要求與技術文檔

MDR 歐盟醫療器材法規-上市後監督系統研習課程

MDR 歐盟醫療器材法規-品質管理系統研習課程

MDR 歐盟醫療器材法規-臨床評估研習課程

MDR上市後監督與臨床評估

MDSAP 內部稽核員訓練課程

人因工程之策略規劃與執行

生物醫學產業輻射滅菌與 EO 滅菌確效研習課程

醫療器材生產製程確效實務研習課程

醫療器材軟體生命週期研習課程